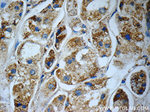
C1QBP Antibody in Immunohistochemistry (Paraffin) (IHC (P))

Search
Proteintech
C1QBP Polyclonal Antibody
{{$productOrderCtrl.translations['antibody.pdp.commerceCard.promotion.promotions']}}
{{$productOrderCtrl.translations['antibody.pdp.commerceCard.promotion.viewpromo']}}
{{$productOrderCtrl.translations['antibody.pdp.commerceCard.promotion.promocode']}}: {{promo.promoCode}} {{promo.promoTitle}} {{promo.promoDescription}}. {{$productOrderCtrl.translations['antibody.pdp.commerceCard.promotion.learnmore']}}

Please note: We are reviewing Western blot images included in the antibody testing data in our catalog, including those provided by third parties. Unless expressly labeled or annotated as “raw-unedited”, Western blot images included in the antibody testing data in our catalog may have been edited, optimized or otherwise adjusted for presentation.
产品信息
24474-1-AP
种属反应
已发表种属
宿主/亚型
分类
类型
抗原
偶联物
形式
浓度
规格
纯化类型
保存液
内含物
保存条件
运输条件
产品详细信息
Immunogen sequence: MLPLLRCVP RVLGSSVAGL RAAAPASPFR QLLQPAPRLC TRPFGLLSVR AGSERRPGLL RPRGPCACGC GCGSLHTDGD KAFVDFLSDE IKEERKIQKH KTLPKMSGGW ELELNGTEAK LVRKVAGEKI TVTFNINNSI PPTFDGEEEP SQGQKVEEQE PELTSTPNFV VEVIKNDDGK KALVLDCHYP EDEVGQEDEA ESDIFSIREV SFQSTGESEW KDTNYTLNTD SLDWALYDHL MDFLADRGVD NTFADELVEL STALEHQEYI TFLEDLKSFV KSQ (1-282 aa encoded by BC013731)
靶标信息
Replication Protein A (RPA) (also known as human single-stranded DNA binding protein, or HSSB) is involved in DNA replication, repair, and recombination. RPA from human cells is a stable heterotrimer of 70kDa, 32-34kDa, and 11-14kDa subunits (RPA70, RPA32, and RPA14 respectively). RPA is required for the SV40 large tumor antigen-catalyzed unwinding of SV40 DNA and stimulates DNA polymerase alpha and delta. RPA34 is phosphorylated at the G1/S boundary of the cell cycle or upon exposure of cells to DNA damage-inducing agents including ionizing and UV radiation.
仅用于科研。不用于诊断过程。未经明确授权不得转售。
生物信息学
蛋白别名: ASF/SF2-associated protein p32; C1qBP; Complement component 1 Q subcomponent-binding protein, mitochondrial; GC1q-R protein; Glycoprotein gC1qBP; Hyaluronan-binding protein 1; Mitochondrial matrix protein p32; p33; RPA; SF2AP32
基因别名: AA407365; AA986492; C1QBP; D11Wsu182e; GC1QBP; gC1qR; HABP1; P32; SF2P32
UniProt ID: (Rat) O35796
Entrez Gene ID: (Rat) 29681, (Mouse) 12261




